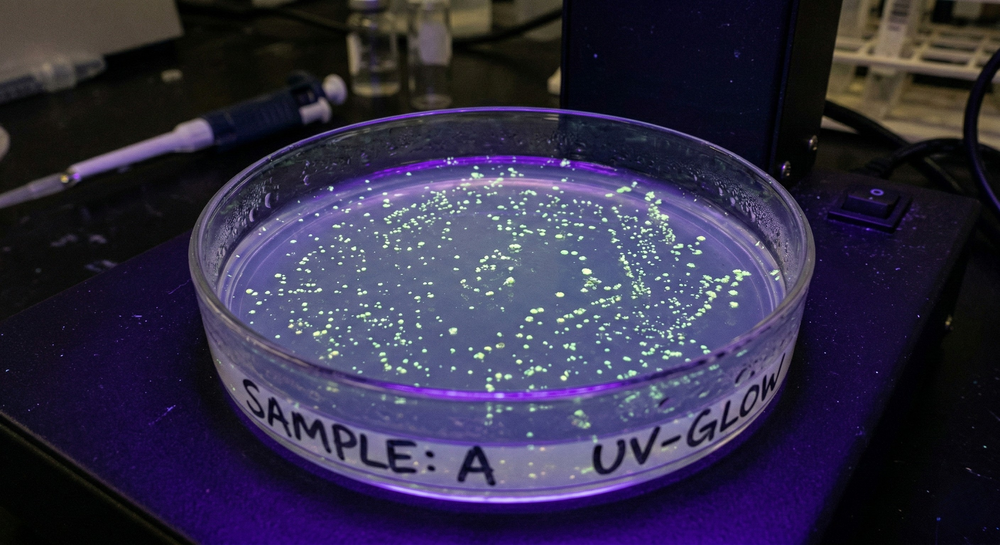

Our advanced UV technology provides clinical-grade sterilization and chemical-free safety that standard cleaners simply cannot match for your peace of mind.

Pure Safety Made Simple
Harmful bacteria cover your everyday items constantly. This powerful sanitizer eliminates germs instantly for peace of mind.
- Eliminates 99% germs
- Fast sanitizing cycle
- Compact and portable
Kills 99.9% Germs
Portable Compact Design
Chemical Free Sanitizing
Fast UV Sterilization
"I had no idea how dirty my toothbrush actually was"
"Saw a video about bathroom bacteria and ordered the same day. Best impulse buy I've made in a while."
— Lotte V. — Amsterdam, Netherlands
✅ Verified Purchase
Clean Your World Effortlessly
-
First Benefit
Eliminates Germs
Kills 99% of bacteria for total safety.
-
Second Benefit
Rapid Action
Disinfects your essentials in just minutes.
-
Third Benefit
Compact Design
Easily fits into your daily routine.

The Superior Choice
|
Puralux
|
Others
|
|
|---|---|---|
|
Clinical Grade
|
|
|
|
Chemical Free
|
|
|
|
Rapid Sanitizing
|
|
|
|
Premium Build
|
|
|
|
Auto-Shutoff
|
|
|
Frequently Asked Questions
Unlike standard cases that trap moisture and breed bacteria, the built-in high-speed fan actively pulls moisture away from the bristles to prevent mildew and unpleasant odors.
Not at all! Unlike liquid disinfectants that can seep into ports or erode protective coatings, this dry light technology is completely safe for electronics. It provides a deep clean for your gadgets while preserving their functionality and appearance, making it the perfect solution for your daily tech essentials.
We know you're busy, so we designed this device for maximum efficiency. A complete sanitization cycle takes just a few minutes, allowing you to quickly refresh your essentials before heading out the door. It is a fast, effortless way to maintain a healthier environment for you and your family.
Absolutely! Its sleek, compact design fits easily into a backpack or carry-on bag, ensuring you have peace of mind wherever you go. Whether you are at the office or in a hotel room, you can enjoy a professional-level clean for your personal belongings anytime, anywhere.